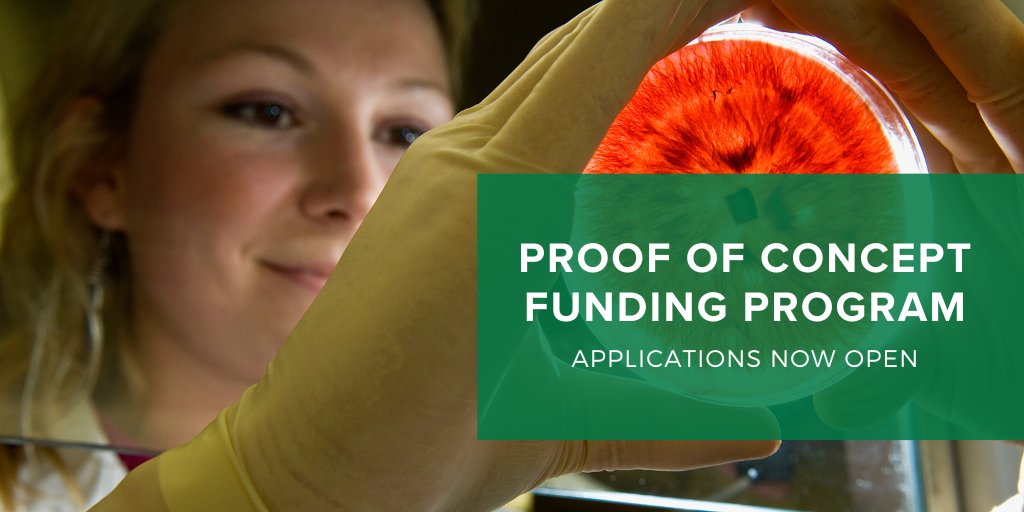
🔬 Applications Open - Proof of Concept Funding Program 🔬

GRDC is seeking proposals for proof-of-concept activities with future R&amp;D pathways to benefit Australian grain growers. Projects can last up to 18 months with a budget of up to $250K.

For more info or to apply visit ▶️

Nirodha.Weeraratne
@nirodhaweerara1
PhD 👩🏾🔬🔬🦠 Plant-soil-microbial interactions, plant pathogens, plant & soil microbiomes, biofilms, microbial inoculants🌾🇱🇰 🇦🇺 firstgen 👩🏾🌾👩👦💃
ID: 1040151416591986688
13-09-2018 08:13:17
4,4K Tweet
917 Followers
1,1K Following




G'day VIC 🇦🇺 grain growers! Do you have paddocks with "weed patches" despite your best efforts in weed control? Are you interested in #PrecisionAg & you've been using spray maps & collecting harvest data? If yes, we'd like to hear from you! [email protected] #NextGenWeedsMgt

🌾 Rice Extension has released the #CY24 Annual Summary! The report captures 📊 Variety yields 🌿 Focus site results💡Key learnings & more. 🔗 bit.ly/4jaAgxL #RiceExtension #CY24 #AusRice #CropData #SustainableFarming #WaterEfficiency #WeedManagement #Ricegrower







🪲Some personal news this #fungalfriday! 👩🏾🔬 I'll be taking about #entomopathogenicfungi infecting #dungbeetles, on Thursday the 27th February 12-1pm at the virtual seminar organised by Australasian Mycological Society. 🔬 To register: australasianmycologicalsociety.com/post/february-… Charles Sturt University Gulbali Institute

Save the date! 🗓️ Thu 27 Feb 12pm AEST/2pm NZST Our February seminar will feature Nirodha Weeraratne Nirodha.Weeraratne from Charles Sturt University entomopathogenic fungi in dung beetles Ecological Society of Australia Plant Pathogens (APPS) Free registration (donations welcome) australasianmycologicalsociety.com/post/february-…





Check out this last piece at National Geographic about how Cordyceps can help to save the world and how my work with Science at VILLUM and NaturalHistoryDK relates to it. nationalgeographic.com/environment/ar… photos by Roberto García-Roa.


🌱 The #Weeds team Charles Sturt University Gulbali Institute is searching for a #PhD candidate to tackle challenges in applying novel weed control tech in Australian cropping systems. 👉 research.csu.edu.au/graduate-resea… #agronomy #weedscience #farmingsystems #AgChatOz


New paper from lab- Microbiome-facilitated plant nutrient acquisition. in Cell Host & Microbe Focusing on emerging insights, we evaluate potential opportunities to harness plant microbiomes & metabolites to sustainably supply nutrients in ecosystems' sciencedirect.com/science/articl…